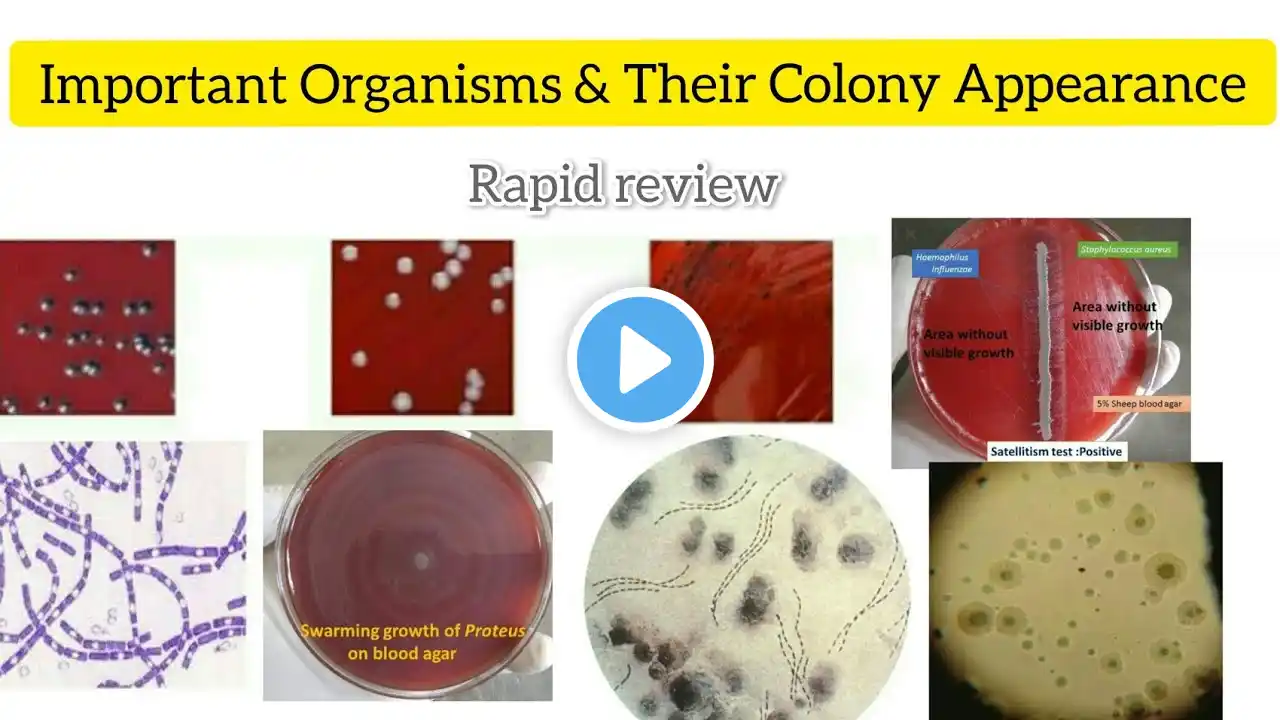
ภาพตัวอย่างวิดีโอ

Rapid Revision Microbiology 🦠🔬 FMGE & NEET-PG by Dr Krishna Sahith
📝Notes:- https://t.me/bhanuprakashdr/1161 📌 𝐅𝐨𝐥𝐥𝐨𝐰 𝐨𝐧 𝐈𝐧𝐬𝐭𝐚𝐠𝐫𝐚𝐦:- / drgbhanuprakash 📌𝗝𝗼𝗶𝗻 𝗢𝘂𝗿 𝗧𝗲𝗹𝗲𝗴𝗿𝗮𝗺 𝗖𝗵𝗮𝗻𝗻𝗲𝗹 𝗛𝗲𝗿𝗲:- https://t.me/bhanuprakashdr 📌𝗦𝘂𝗯𝘀𝗰𝗿𝗶𝗯𝗲 𝗧𝗼 𝗠𝘆 𝗠𝗮𝗶𝗹𝗶𝗻𝗴 𝗟𝗶𝘀𝘁:- https://linktr.ee/DrGBhanuprakash Rapid Revision Microbiology 🦠🔬 FMGE & NEET-PG by Dr Krishna Sahith This Rapid Revision Microbiology 🦠🔬 lecture by Dr Krishna Sahith is a high-yield, exam-focused crash revision session designed specifically for FMGE and NEET-PG aspirants, and is equally useful for MBBS students, INI-CET, NEXT and USMLE preparation 👨⚕️📖. The session is structured to help students revise vast microbiology content quickly and effectively with a strong focus on MCQ-oriented concepts. The lecture covers core areas of microbiology, including bacteriology 🧫, virology 🧬, mycology 🍄, parasitology 🪱 and immunology 🛡️, with emphasis on organisms of exam importance, virulence factors, pathogenesis, laboratory diagnosis, culture media, toxins, vaccines, and antimicrobial correlations. Frequently tested organisms such as Staphylococcus, Streptococcus, Mycobacterium, Enterobacteriaceae, viruses, fungi and parasites are revised in a simplified and exam-relevant manner. Special attention is given to high-yield tables, differentiating features, one-liners, images-based questions, and recent exam trends, making this lecture ideal for last-minute revision ⚡, rapid consolidation, and boosting exam confidence. The teaching style focuses on concept clarity with recall-friendly explanations, helping students avoid common mistakes in competitive exams. This lecture is suitable for a global medical audience 🌍, including Indian and international medical graduates, and aligns well with the exam patterns of FMGE, NEET-PG, INI-CET, NEXT and USMLE Step 1. It serves as an excellent single-sitting microbiology revision resource before exams. This lecture covers all key microbiology topics essential for FMGE, NEET-PG, MBBS and competitive medical entrance examinations, making it a must-watch rapid revision video. 📚 Join us for an EPIC Rapid revision session on Microbiology! 🎥 👨⚕️ Calling all FMGE and NEET PG aspirants! 🏥 🔥 Get ready to ace your exams with us! We've got you covered with: ✅ High-yield points ✅ Most commonly expected exam topics ✅ Previous year questions (PYQs) ✅ Important bonus questions (IBQs) Don't miss out on this invaluable revision session. 🚀 Subscribe now and hit the notification bell to stay updated! 📲 Let's conquer those exams together! 💪 💉🧠📖 #fmge #fmgevideos #rapidrevisionfmge #fmgejan2023 #mbbslectures #nationalexitexam #nationalexittest #neetpg #usmlepreparation #usmlestep1 #fmge #usmle #drgbhanuprakash #medicalstudents #medicalstudent #medicalcollege #neetpg2023 #usmleprep #usmlevideos #usmlestep1videos #medicalstudents #neetpgvideos #microbiology #rapidrevisionfmge #rapidrevisionseries #rapidrevisionmicrobiology #microbiologyneetpg #microbiologyfmge #Microbiology #RapidRevision #MicrobiologyRevision #FMGE #NEETPG #INICET #NEXTExam #USMLE #USMLEStep1 #MBBS #MedicalStudents #MedicalMicrobiology #Bacteriology #Virology #Mycology #Parasitology #Immunology #HighYieldTopics #LastMinuteRevision #ExamPreparation #MedicalEducation #MedEd #IMG #InternationalMedicalGraduate #DrKrishnaSahith